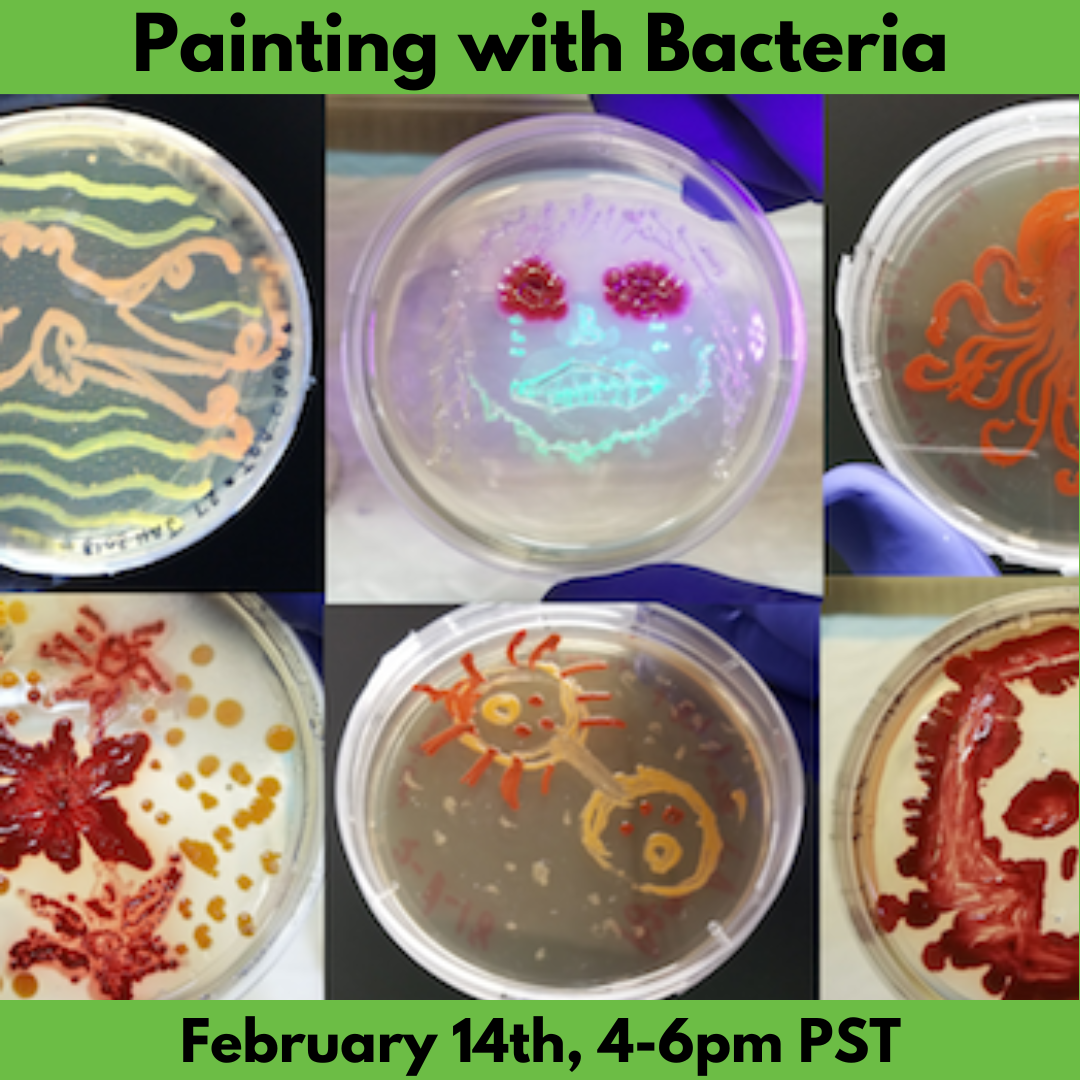
Painting with Bacteria

Interested in making microbial masterpieces? In this workshop, we will create bacteria-based paint with strains transformed to glow in various colors. Don’t worry—all our bacteria are human-safe/non-pathogenic. From these paints, you’ll be able to make your own living masterpieces within a petri dish!
Note we will send you pictures of their growth, you are also free to arrange a visit back within a few days to see how your work developed in person.
Purchase tickets here and become a member here. Fee waivers are available if the cost is prohibitive. You can apply for a fee waiver via this form. Questions? Email workshops@sound.bio.